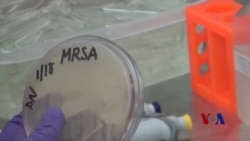
微小机器人未来或可进入人体消灭超级病菌

将近80年来,科研人员一直在开发抗生素,杀死致命细菌。不幸的是,病菌能够很快适应,有些演变为能够抵抗所有抗生素的超级病菌,而制造新药却是一个长期、昂贵和复杂的进程。因此,科罗拉多大学生物前沿研究所的科研人员把眼光放得更远,越过以生物为基础的药物。他们开发的是“量子点”抗生素。
这些培养皿内有着一些世界最危险的微生物。科罗拉多大学的科学家阿努什·查特吉说,这是因为它们带有传统药物难以克服的超级病菌。
她说:“在某些情况下,它们对20多种抗生素具有耐药性。面对抗生素,它们不仅能够生存,实际上还能茁壮成长。”
开发以生物为基础的传统抗生素需要多年的时间。查特吉的丈夫和同事普拉尚特·纳格帕尔说,人类正在输掉与超级病菌的竞赛。
他说:“让我们开发一种在适应速度方面即使不会超过微生物但至少能够保持一致的系统。”
为了达到这样的目标,纳格帕尔的实验室分析了超级病菌的DNA,然后研制了一种针对性极强的抗生素,而且所需时间不用数年,只要数天。他的方式是使用从被称为“量子点”的半导体微粒中制造抗生素的机器。
他说:“我们每次想到半导体,就会觉得它会用于摄像机,不过,你可以用同样的半导体,把它缩小,放入细胞内。”
每个量子点都比一个活体细胞小两万倍。纳格帕尔的研究团队把数以百万计的量子点混入管中,并精密调整它们的属性。紫外光显示了不同的种类。纳格帕尔说,在遏止超级病菌方面,这个小小的管子里蕴藏着巨大的威力。
他说:“这非常有可能你所需要的整个疗法。”
纳格帕尔说,一旦激活,这些量子点抗生素释放出原子大小的自由基,专门打击那些它们按照事先设计要去杀死的超级病菌。这些量子点把简单的物质变成了一颗颗微小的导弹。
他说:“它们只是使用氧气和水,生成这些自由基物种,专门伤害这些微生物,却不会伤害我们哺乳动物的细胞、我们的宿主、我们的人体细胞。”
研究人员对蛔虫使用了这些量子点。这些蛔虫通常都抵御不住超级病菌。查特吉说,量子点杀死了那些致命的微生物,却没有对蛔虫造成任何伤害。
她说:“这个具体方式真的可以消灭相当大一部分的临床菌株,这些临床株具有非常高的耐药性。”
查特吉和纳格帕尔说,在确保这些量子点可以用于人类之前,还需要多年的试验。不过,到目前为止的结果让他们看到希望,相信有一天他们的半导体微粒将会帮助医生们跟上飞速演变的超级病菌,治病救人。